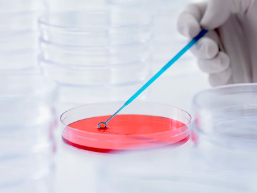
image.png

揚州干細胞存儲哪家更可靠,需要注意哪些事項
2024-11-16 15:21:29 來源: 小編 咨詢醫(yī)生
本文將深入探討揚州地區(qū)干細胞存儲的可靠性問題,并為讀者提供在選擇干細胞存儲機構(gòu)時需要注意的關鍵事項。
干細胞存儲作為一種新興的生物技術(shù),在我國得到了越來越多的關注。揚州作為一個發(fā)展迅速的城市,也涌現(xiàn)出了多家干細胞存儲機構(gòu)。那么,在這些機構(gòu)中,哪家更可靠呢?以下是幾個評估標準以及需要注意的事項。
一、評估標準
1.專業(yè)資質(zhì)
在選擇干細胞存儲機構(gòu)時,首先要關注其是否具備相關資質(zhì)。在我國,干細胞存儲機構(gòu)需要獲得衛(wèi)生健康部門的批準,并具備相應的生物技術(shù)資質(zhì)。具備這些資質(zhì)的機構(gòu),才能保證其在技術(shù)、設備和人員方面的專業(yè)性。
2.技術(shù)實力
干細胞存儲涉及復雜的生物技術(shù),因此,機構(gòu)的技術(shù)實力至關重要。一家可靠的干細胞存儲機構(gòu)應具備先進的凍存技術(shù)、完善的實驗室設備和嚴謹?shù)牟僮髁鞒?,確保干細胞的安全存儲。
3.服務質(zhì)量
服務質(zhì)量是衡量干細胞存儲機構(gòu)可靠性的另一個關鍵因素。優(yōu)質(zhì)的服務包括為客戶提供詳盡的咨詢、專業(yè)的存儲方案、完善的售后服務等。
二、需要注意的事項
1.合同條款
在選擇干細胞存儲機構(gòu)時,務必仔細閱讀合同條款。合同中應明確雙方的權(quán)利和義務,包括存儲期限、費用、保密條款等。確保合同內(nèi)容合法合規(guī),以免日后產(chǎn)生糾紛。
2.存儲費用
存儲費用是選擇干細胞存儲機構(gòu)時不可忽視的因素。不同機構(gòu)的存儲費用可能存在差異,消費者應根據(jù)自己的經(jīng)濟條件進行選擇。同時,要了解清楚費用包含哪些服務,避免后期產(chǎn)生額外費用。
3.信息安全
干細胞存儲涉及到個人隱私,因此,在選擇機構(gòu)時要關注其信息安全措施。確保機構(gòu)具備完善的信息保密制度,保障客戶隱私不被泄露。
4.后續(xù)服務
干細胞存儲并非一勞永逸,后續(xù)服務同樣重要。了解機構(gòu)是否提供定期檢查、凍存報告等服務,以便隨時了解干細胞存儲狀況。
綜上所述,揚州地區(qū)的干細胞存儲可靠性評估,可以從專業(yè)資質(zhì)、技術(shù)實力、服務質(zhì)量等方面進行。在選擇干細胞存儲機構(gòu)時,消費者需關注合同條款、存儲費用、信息安全以及后續(xù)服務等方面,確保自己的權(quán)益得到保障。在此,祝愿廣大消費者能夠選擇到一家可靠的干細胞存儲機構(gòu),為自己的健康保駕護航。
-
上一頁: 新生兒干細胞存儲有必要嗎,有哪些注意事項
-
下一頁: 如何進行干細胞儲存過程,步驟有哪些要注意
- 2024-10-11干細胞存儲費用,干細胞存儲的意義是什么
- 2024-08-06存儲干細胞費用,存儲干細胞有什么用
- 2024-12-07海南新生兒干細胞存儲費用多少,性價比如何
- 2024-08-20干細胞存儲必要性,為什么越早越好
- 2024-12-02胎盤造血干細胞儲存有必要嗎,有何優(yōu)勢
- 2024-09-06湖北牙髓干細胞儲存費用是多少
- 2024-09-07干細胞生物治療腫瘤效果好嗎,一般要花多少錢
- 2024-09-22山東省臍帶血造血干細胞庫怎么樣
- 2024-07-29干細胞的分化過程,干細胞的分化程度高嗎
- 2024-08-19間充質(zhì)干細胞抗衰老靠譜嗎,抗衰作用機制介紹
- 2024-09-16韌帶干細胞療法再生有效果嗎,原理是什么
- 2024-09-27廣東貝拉國際醫(yī)療怎么樣
- 2024-09-02甲狀腺干細胞再生療法有哪些
- 2024-07-30臍帶間充質(zhì)干細胞存儲費用,臍帶間充質(zhì)干細胞需要配型嗎
- 2024-08-21干細胞治療小兒自閉癥效果如何,是否值得嘗試
- 2024-09-04干細胞牙齦種植費用大概多少錢一顆
- 2024-08-27造血干細胞是干什么的,解析其治療潛力和應用
- 2024-07-29干細胞的分化過程,干細胞的分化程度高嗎
